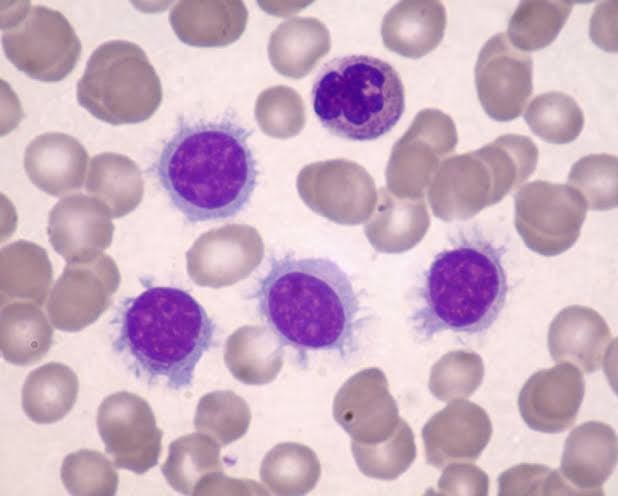

Afiliaciones y Sociedades Médicas
Formo parte de varias sociedades médicas que respaldan mi compromiso con la excelencia y la actualización constante en el campo de la salud.
Sociedad Dominicana de Hematología
Sociedad Española de hematología y hemoterapia
Sociedad Española de Hemostasia y trombosis
European hematology society
Sociedad Británica de Hematologia
Grupo Clath
Grupo Gell
Grupo Glam
International Myeloma Society

ARS
ARS Humano
ARS Primera
ARS Senasa
ARS Futuro
ARS Mapfre
ARS Universal
ARS Monumental
ARS IDOPPRIL
ARS Reservas
ARS CMD
Imágenes de frotis y de medulograma
Diferentes imágenes de como se ven las células en el miscropio y en la médula ósea

@dra.erimargrullon
Sobre mí
Hola! Soy la Dra. Erimar Grullón
Estaremos compartiendo contigo contenido de valor, orientado a educar y concienciar sobre la prevención y el conocimiento de algunas enfermedades de la sangre.
• ¿Quién soy?
Soy egresada de la PUCMM, con un postgrado en Hematología en el Hospital Clínico Quirúrgico
Hermanos Ameijeiras Avalado por la Universidad de Ciencias
Médicas de la Habana Cuba.
Diplomado en auditoría médica, Diplomado en pedagogía. 10 años de constante aprendizaje y trabajo en el sector de la salud, trabajo en equipo, calidez en el servicio, capacidad de adaptación y disposición para enfrentar los retos.




Participación
Talleres de trasplante de células progenitoras hematopoyéticas.
Curso manejo de redes sociales en Infotep.
Taller del mieloma múltiple en el covid-19.
Taller actualización en trombocitopenia inmune.
Taller manejo de la hemostasia durante la infección por covid-19.
Curso prehabilitación del paciente quirúrgico.
Curso actualización en el tratamiento del mieloma múltiple, workshop síndromes linfoproliferativos.
entrenamiento en trasplante de células progenitoras
hematopoyeticas
Diplomado en hemostasia y trombosis
Diplomado en banco de sangre
.Diplomado 360 de hematología
Nuestros servicios
Atención integral en el diagnóstico y tratamiento de los tractions y enfermedades de la sangre


Consulta y evaluación especialida
Evaluación personalizada para cada paciente.
Extendido de sangre periférica
Biopsia de médula ósea y medulograma
Pruebas precisas para detectar trastornos.
Tratamientos
Planes adaptados a tus necesidades específicas.
Únete a mi página
Recibe consejos y novedades sobre salud hematológica
Contacto
Consulta tus dudas con la Dra. Erimar Grullón
Teléfono
dragrullon@outlook.com
© 2025. All rights reserved.
